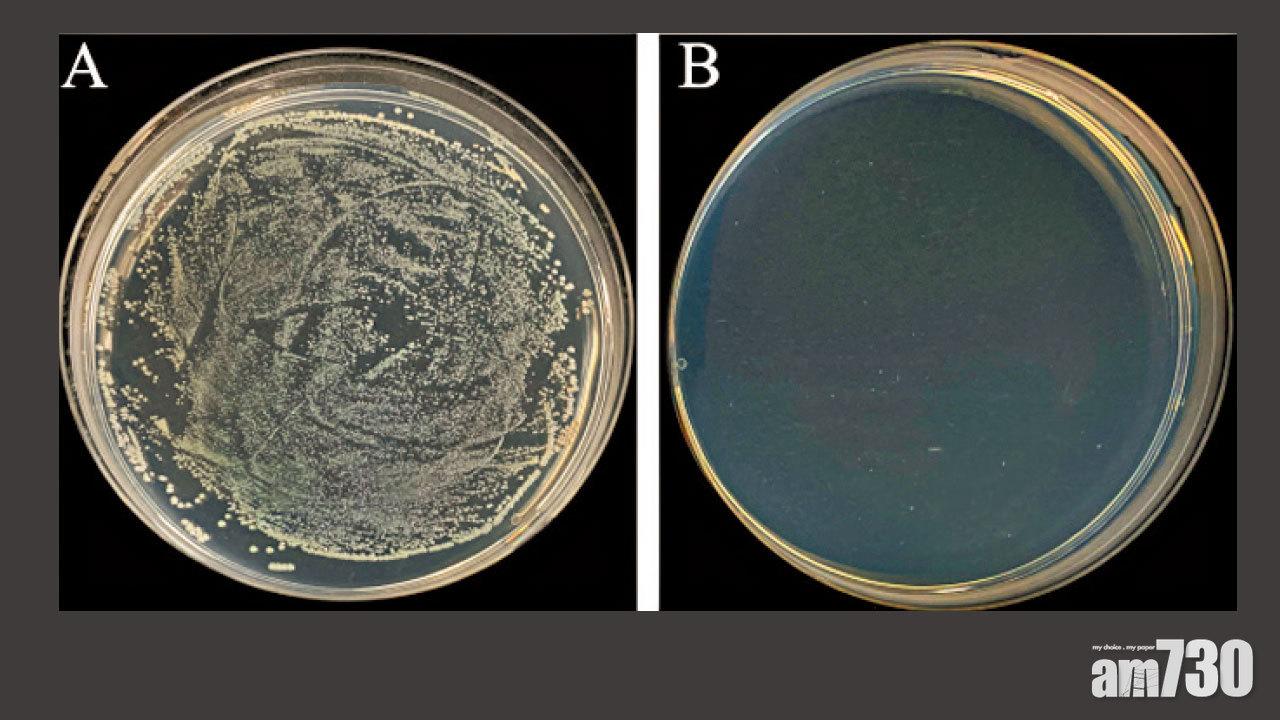

普通不銹鋼菌落數(左)和高銅不銹鋼菌落數(右),有明顯分別。 (港大圖片)

升降機按扭、門柄等,不少以不銹鋼製造,有研究發現,新冠病毒殘留在不銹鋼表面3天後仍具感染力。香港大學跨學院團隊研發出高銅含量不銹鋼,能成功殺滅存留於其表面的新冠病毒、甲型流感病毒以及大腸杆菌,是全球已知首個自身表面可殺滅新冠病毒的不銹鋼。團隊指,新物料可用於醫院及檢疫酒店等高風險場所,以減低職員及清潔工受感染的機會,並可用於製造醫療儀器。

黃明欣指,與業界合作用新不銹鋼製備如電梯按鈕等的原型作測試。(莊振邦攝)
高銅含量不銹鋼由港大工程學院機械工程系教授黃明欣領導的團隊,與港大李嘉誠醫學院免疫與感染研究中心潘烈文教授的研究團隊合作,通過調整不銹鋼的化學成分和微觀組織結構,成功令不銹鋼表面有殺滅病毒功效;發現高銅不銹鋼表面能最快在3小時內殺滅逾99.97%的新冠病毒,6小時更達99.99%。

黃明欣指,在研究測試時,調節不同銅比例,「5%以下是不可以,而(銅比例)10%及20%均可以,20%會好過10%,但再上就(成本)更貴。」高銅含量不銹鋼使用數年仍具效能,即使用清潔劑等清潔表面,亦抹不走銅粒子。
港大公共衛生學院潘烈文表示,科學界已知銅可殺滅病毒,但背後的原理有待再研究,而團隊研究發現,新冠病毒黏上銅質表面便會慢慢降低傳播能力。未來亦會研究新研發的不銹鋼是否對Omicron等變種病毒有效。
團隊正就抗新冠病毒不銹鋼申請國際專利。團隊計劃與工業界合作,利用新不銹鋼製備在公共場所中廣泛應用的不銹鋼電梯按鈕、門把手和扶手等的原型作測試,有望進一步把研發成果工業化生產和商品化。

相關產品可用於替換公共場所中一些頻繁接觸的常規不銹鋼產品,以降低公眾感染的風險,對抗當前的新冠疫情。潘烈文補充指,該物料可用於醫院及檢疫酒店等高風險場所,以減低職員及清潔工受感染的機會,並可用於製造醫療儀器。
















